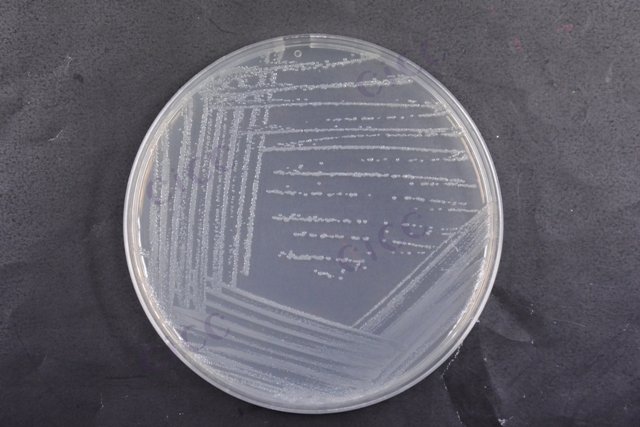
唐菖蒲伯克霍尔德氏菌 Burkholderia gladioli CICC 10574 Burkholderia gladioli

唐菖蒲伯克霍尔德氏菌 Burkholderia gladioli CICC 10574 Burkholderia gladioli
-
唐菖蒲伯克霍尔德氏菌 Burkholderia gladioli CICC 25108 Burkholderia gladioli
CICC 25108 | 见证书
-
唐菖蒲伯克霍尔德氏菌 Burkholderia gladioli
BNCC362154 | 冻干粉;斜面;菌液;平板
-
唐菖蒲伯克霍尔德氏菌 Burkholderia gladioli (Severini 1913) Yabuuchi et al. 1993
BNCC354544 | 冻干粉;斜面;菌液;平板
-
唐菖蒲伯克霍尔德氏菌DNA标准品 Burkholderia gladioli DNA standard
BNCC370539 | 冻存管;(7.5±1.5)×10^6copies/mL;5管/盒
-
唐菖蒲伯克霍尔德氏菌DNA标准品 Burkholderia gladioli DNA standard
BNCC363690 | 冻存管
-
唐菖蒲伯克霍尔德氏菌DNA标准品 Burkholderia gladioli DNA standard
BNCC363689 | 冻存管
-
唐菖蒲伯克霍尔德氏菌DNA标准品 Burkholderia gladioli DNA standard
BNCC370541 | 冻存管

说明书下载: 菌种说明书 打管说明书
您正在浏览的产品:唐菖蒲伯克霍尔德氏菌 Burkholderia gladioli CICC 10574
手机版:唐菖蒲伯克霍尔德氏菌 Burkholderia gladioli CICC 10574
本公司销售的所有产品仅供实验科研使用,不用于人体及临床诊断。
2. 选择性培养:分离可疑菌落;
3. 生化鉴定:包括过氧化氢酶、尿素酶等试验;
4. 血清凝集试验:确认菌株特异性抗原[3][6]。
以上信息仅供参考,请以相应标准的原文为准!